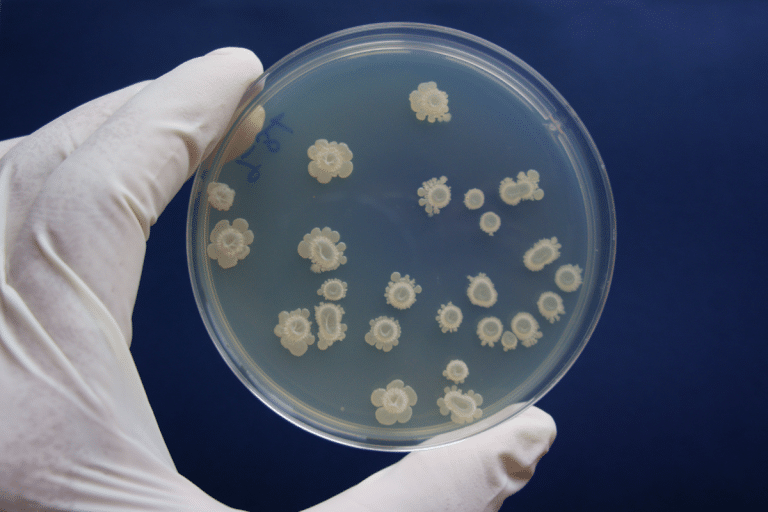
Bactéria multirresistente que representa risco global de saúde é detectada no Nordeste

Cepa de ‘Klebsiella pneumoniae’ havia sido identificada previamente nos Estados Unidos. Microrganismo costuma causar infecções em ambiente hospitalar e não é eliminado por nenhum antibiótico existente, sendo particularmente perigoso para pessoas com baixa imunidade
Uma cepa da bactéria Klebsiella pneumoniae isolada de uma mulher de 86 anos com infecção urinária, admitida em um hospital em uma cidade da região Nordeste em 2022, mostrou-se resistente a todas as opções de antibióticos disponíveis. A paciente faleceu 24 horas após a admissão naquele centro de saúde.
Um grupo de pesquisadores apoiado pela Fapesp sequenciou o genoma da bactéria e comparou com um banco de dados de 408 outras sequências parecidas. O resultado é alarmante. Trata-se de uma cepa detectada anteriormente nos Estados Unidos e que já estava circulando no Brasil, com risco de se espalhar pelo mundo.
Os resultados foram publicados na revista The Lancet Microbe.
“Ela é tão versátil que se adapta às mudanças de tratamento, já que adquire facilmente outros mecanismos de resistência não contemplados pelas drogas existentes ou pela combinação delas. É possível que se torne endêmica nos centros de saúde em nível mundial”, alerta Nilton Lincopan, professor do Instituto de Ciências Biomédicas da Universidade de São Paulo (ICB-USP) e coordenador do estudo.
O pesquisador coordena a One Health Brazilian Resistance (OneBR onehealthbr.com), plataforma que reúne dados epidemiológicos, fenotípicos e informações genômicas de microrganismos classificados pela Organização Mundial da Saúde (OMS) como de “prioridade crítica”.
Essa classificação contempla bactérias com escassas opções terapêuticas disponíveis e que merecem medidas de contenção para não serem disseminadas, além de terem prioridade para a pesquisa e desenvolvimento de novos antimicrobianos.
A plataforma tem apoio da Fapesp, do Conselho Nacional de Desenvolvimento Científico e Tecnológico (CNPq) e da Fundação Bill e Melinda Gates.
Quando encontram cepas multirresistentes como essa, os serviços de saúde devem notificar a vigilância epidemiológica local. O paciente deve ser isolado e a equipe que o trata deve tomar cuidados redobrados para não transmitir a bactéria para outros pacientes.
“Como patógeno oportunista, em pacientes com imunidade normal a bactéria pode nem causar doença. Mas, em pessoas com imunidade baixa, pode ocasionar infecções graves. Em nível hospitalar, pacientes internados em unidades de terapia intensiva [UTIs] ou em tratamento para outras patologias podem adquirir infecção secundária, como pneumonia. Sem tratamentos disponíveis e com o sistema imune deprimido, muitas vezes podem ir a óbito”, conta o pesquisador.
Favorecida pela pandemia
Os autores notam que cepas coprodutoras de carbapenemases (enzimas capazes de hidrolisar compostos antimicrobianos) como essa, resistentes a todos os beta-lactâmicos, classe mais utilizada de antibióticos, passaram a ser largamente detectadas durante a pandemia da Covid-19 em países da América Latina e Caribe.
Os achados geraram um alerta epidemiológico pela Organização Pan-Americana de Saúde (OPAS) e pela OMS. Uma análise genômica global publicada recentemente por um grupo liderado por Fábio Sellera, professor da Universidade Metropolitana de Santos, registrou ainda uma rápida evolução dessas bactérias, ressaltando uma nova tendência de resistência e um sério problema de saúde pública.
O medicamento de última geração ceftazidima/avibactam, indicado para o tratamento de bactérias críticas para saúde, como K. pneumoniae produtora de carbapenemase (KPC), foi liberado pela agência norte-americana que regula medicamentos (FDA) em 2015.
Sua aprovação de registro pela Agência Nacional de Vigilância Sanitária (Anvisa) ocorreu em 2018, por conta do grande número de infecções registradas por KPC.
“Muito provavelmente, internações por Covid-19 associadas a infecções secundárias por esse tipo de bactéria levaram a um aumento global no uso de ceftazidima/avibactam, favorecendo o aparecimento de cepas resistentes a este novo antibiótico”, diz Lincopan.
O procedimento padrão seria que pacientes admitidos com suspeita de infecção bacteriana tivessem seu material clínico coletado para confirmar o diagnóstico e testada a suscetibilidade aos diferentes antimicrobianos disponíveis.
“Provavelmente, cepas produtoras de KPC tratadas com ceftazidima/avibactam evoluíram rapidamente, adquirindo mecanismos de resistência para esta última opção terapêutica. Agora, temos cepas coprodutoras de carbapenemases que não respondem ao tratamento por beta-lactâmicos”, lamenta.
Além do monitoramento permanente das cepas bacterianas encontradas nos hospitais, os pesquisadores ressaltam a importância da prescrição racional dos antibióticos. Atualmente, a plataforma OneBR conta com 700 genomas de patógenos humanos e animais em seu banco de dados.
Para os pacientes, a mensagem é que, quando tiverem antibióticos prescritos para si, façam o tratamento até o fim, mesmo que se sintam bem após dois ou três dias. A prática também evita o surgimento de cepas resistentes.
O trabalho, que teve como primeiro autor o doutorando Felipe Vásquez Ponce, do ICB-USP, foi apoiado ainda por meio de bolsa de doutorado para Johana Becerra na mesma instituição.
Fonte: labnetwork